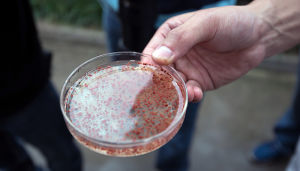
巧用科技治水

概述
厭氧氨氧化菌包括(Candidatus Brocadia)、(Candidatus Kuenenia)和(Candidatus Scalindua)屬。
它們至今未能成功分離得到純菌株,因此尚未獲得正式命名和分類。它們可以在缺氧環境中,將銨離子(NH4+)用亞硝酸根(NO2-)氧化為氮氣:
NH4+ + NO2- → N2 + 2 H2O, ΔGo = -357 kJ mol-1
生物特性
它們對全球氮循環具有重要意義,也是污水處理中重要的細菌。
在厭氧氨氧化過程中,羥胺和肼作為代謝過程的中間體。和其它浮黴菌門細菌一樣,厭氧氨氧化菌也具有細胞內膜結構,其中進行氨厭氧氧化的囊稱作厭氧氨氧化體(anammoxoxome),小分子且有毒的肼在此內生成。
厭氧氨氧化體的膜脂具有特殊的梯烷(ladderane)結構,可阻止肼外泄,從而充分利用化學能,且避免毒害細胞。
形態特徵
形狀大小
 厭氧氨氧化菌
厭氧氨氧化菌細胞內
細胞內分隔成3部分:厭氧氨氧化體(anammoxosome)、核糖細胞質(riboplasm)及外室細胞質(paryphoplasm)。核糖細胞質中含有核糖體和擬核,大部分DNA存在於此。厭氧氨氧化體是厭氧氨氧化菌所特有的結構,占細胞體積的50%-80%,厭氧氨氧化反應在其內進行。厭氧氨氧化體由雙層膜包圍,該膜深深陷入厭氧氨氧化體內部。
細胞壁
厭氧氨氧化菌的細胞壁主要由蛋白質組成,不含肽聚糖。細胞膜中含有特殊的階梯烷膜脂,由多個環丁烷組合而成,形狀類似階梯。在各種厭氧氨氧化菌中,階梯烷膜脂的含量基本相似。疏水的階梯烷膜脂與親水的膽鹼磷酸、乙醇胺磷酸或甘油磷酸結合形成磷脂,構成細胞膜的骨架。
細胞膜中的非階梯烷膜脂由直鏈脂肪酸、支鏈脂肪酸、單飽和脂肪酸和三萜系化合物組成。曾一度認為階梯烷膜脂只存在於厭氧氨氧化體的雙層膜上,其功能是限制有毒中間產物的擴散。認為階梯烷膜脂存在於厭氧氨氧化菌的所有膜結構上(包括細胞質膜),它們與非階梯烷膜脂相結合,以確保其他膜結構的穿透性好於厭氧氨氧化體膜。
生理生化
厭氧氨氧化菌為化能自養型細菌,以二氧化碳作為唯一碳源,通過將亞硝酸氧化成硝酸來獲得能量,並通過乙醯-CoA途徑同化二氧化碳。雖然有的厭氧氨氧化菌能夠轉化丙酸、乙酸等有機物質,但它們不能將其用作碳源。厭氧氨氧化菌對氧敏感。
套用技術
巧用科技治水
巧用科技治水首先,厭氧氨氧化菌的出現“模糊了細菌的定義”。因為DNA的研究將它們明確歸類為細菌屬,但是他們的內部細胞器使它們更像真菌。同時,該微生物細胞壁中缺少剛性聚合肽聚糖,這使得它們又類似於單細胞膜的古菌。所以Strous說“它們的出現模糊了細菌的定義”。
其次,厭氧氨氧化現象的發現,使全球氮循環也發生變化,因為厭氧氨氧化在整個循環過程中走了個捷徑,創造了一個由氨和亞硝直接轉換成氮氣的途徑。
最後,厭氧氨氧化技術一旦成熟,那么它將以其自身強大的優勢迫使“污水處理工藝的改變”。

